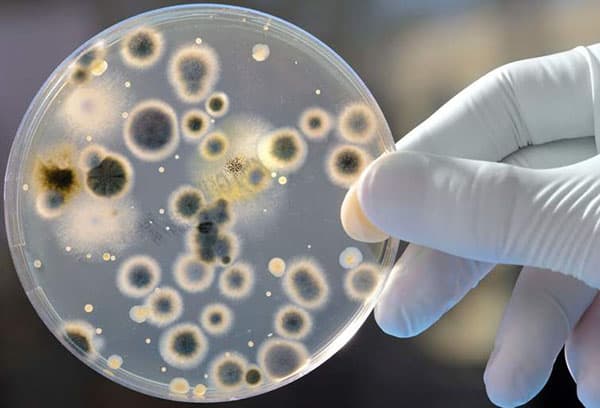
Moisissure

5 meilleurs remèdes contre la moisissure sur les murs
Contenu:
Ne croyez pas les gens qui disent qu'il est impossible de se débarrasser complètement du champignon et de la moisissure sur les murs, que tout remède ne résout que temporairement le problème, mais que tout recommence bientôt. Bien sûr, si vous achetez le premier fongicide qui vous est proposé, traitez-le avec une surface non préparée et trouvez le problème résolu, c'est exactement ce qui se passera - des taches apparaîtront bientôt à nouveau sur le papier peint. Pour détruire complètement le moule, vous devrez faire beaucoup d'efforts et de temps. À l'avenir, il faudra observer des mesures préventives et inspecter périodiquement les structures des bâtiments: le champignon est très insidieux, il peut se cacher dans n'importe quelle fissure microscopique et recommencer un travail destructeur.
Comment comprendre qu'un champignon s'est retrouvé à la maison?
Un ennemi insidieux peut prendre une forme différente. Les mots "champignon" et "moisissure" sont appelés colonies de micro-organismes. Ils ont des dimensions microscopiques, vous ne pouvez pas les voir à l'œil nu. Les taches visibles consistent en un grand nombre de minuscules champignons. Selon leur type, la plaque a une couleur différente:
- le bol blanc se répand le plus souvent à partir d'un sol trop humide dans des pots de fleurs;
- vert va généralement aux matériaux de construction avec de la nourriture;
- le bleu aime s'installer sur des structures en bois;
- le noir vit sur toutes les surfaces.
Il convient également d'alerter le pelage des matériaux de finition des murs, la destruction du plâtre. Tout d'abord, la peinture gonfle et s'écaille, puis le ciment ou la brique, réduite en poussière, commence à couler de dessous. Une telle image peut être observée à la fois à l'intérieur du bâtiment et sur la façade. Si vous laissez le problème sans surveillance, les structures porteuses commenceront à s'effondrer, la maison se détériorera et risque de s'effondrer.
Le champignon ne s'installe pas toujours sur des surfaces ouvertes - il aime l'humidité et l'air calme. Souvent, de telles conditions se rencontrent dans des endroits difficiles d'accès: derrière les meubles, sous les tapis, dans les placards, derrière une salle de bains et un lavabo. Dans ce cas, une odeur peut vous avertir du danger. Si vous sentez que ça sent comme un sous-sol humide sous un certain angle, éloignez tous les objets gênants des murs et recherchez les endroits suspects.
Les personnes sujettes aux allergies sont les premières à être informées de l'apparition de moisissures. Si auparavant ils étaient tranquillement dans l'appartement, et récemment ils ont commencé à se plaindre de nez qui coule, de larmes, de démangeaisons, peut-être qu'ils ont senti la propagation du champignon. Les animaux domestiques peuvent être malades et mourir dans une pièce infectée. Si vous remarquez une détérioration du bien-être de n'importe quel habitant de la maison, recherchez la présence du champignon et prenez des mesures préventives pour empêcher son apparition. Au début, les toxines libérées par les moisissures affectent les organismes faibles, mais lorsqu'une colonie se développe, une personne en bonne santé peut tomber malade. Ne vous attendez pas à des manifestations plus perturbantes, prenez des mesures dès les premiers symptômes de l'infection.
Se débarrasser de la moisissure par des méthodes traditionnelles
Jusqu'à ce que le champignon pénètre profondément dans la structure du bâtiment, vous pouvez essayer de le gérer sans l'aide de la chimie. Auparavant, la créosote ou l'eau de Javel était utilisée à ces fins, mais ce n'est plus nécessaire. Les composés sont toxiques. Après plusieurs jours, il est impossible de se débarrasser de l’odeur dégueulasse. Les médicaments modernes sont pratiques à utiliser, plus efficaces et moins nocifs.
Si vous voulez agir par des méthodes folkloriques, vous pouvez utiliser les outils suivants.
- Le vinaigre - convient à toutes les surfaces.
- Solution de soude (1 h.cuillère sur un verre d'eau) - pour les matériaux qui ne craignent pas le contact avec un alcali.
- Ammoniac liquide - il est dilué avec de l'eau dans un rapport de 1: 1 et utilisé sur des revêtements lisses qui n'absorbent pas l'humidité.
- Huile de théier (1 cuillère à thé par verre d'eau) - aide à éliminer les champignons, désinfecte la pièce et neutralise les odeurs désagréables.
- Le peroxyde d'hydrogène - décolore la couleur, il est préférable de l'utiliser dans les zones lumineuses.
Commencez par nettoyer le revêtement de la poussière, de la saleté et de la plaque que vous pouvez enlever avec un chiffon humide. Ensuite, aspirez une solution aqueuse de ces substances dans le flacon pulvérisateur et vaporisez la surface affectée. Utilisez un chiffon pour éliminer les moisissures, mais ne séchez pas. L’humidité restante pénètrera dans les pores et les microfissures et détruira les micro-organismes qui y sont installés. Après une heure, faites un nettoyage en profondeur, ventilez bien la pièce afin que l'air dans la pièce devienne sec. Avec cette méthode, les remèdes traditionnels contre les moisissures aideront à éliminer un champignon récemment apparu.
Répéter le traitement chaque semaine pendant au moins 1,5 mois. N'oubliez pas qu'il est indésirable de respirer deux par deux, même avec les préparations ménagères, de porter des gants, de protéger vos yeux avec des lunettes et les voies respiratoires avec un bandage de gaze de coton. Le champignon peut s’installer dans n’importe quel appartement. Par conséquent, à des fins préventives, ajoutez l’une de ces substances à l’eau. Le fait est que les spores de moisissures sont très petites, elles volent dans l'air ambiant et sont présentes sur n'importe quelle surface. La seule chose qui nous épargne est le besoin d'humidité et d'autres conditions vitales pour la moisissure.
Top 5 des remèdes contre la moisissure sur les murs
Si le raid s'est étendu sur une grande surface, le moule a déjà réussi à pénétrer profondément dans les structures du bâtiment. Les remèdes populaires n’aideront plus, pour combattre l’ennemi dont vous avez besoin pour acquérir une composition plus forte. Dans les départements de chimie ménagère, vous verrez toute une étagère composée de divers médicaments antifongiques. Votre tâche consiste à trouver l’arme la plus efficace et la plus sûre.
Afin que le travail ne soit pas gaspillé, choisissez, dans le champignon situé sur les murs, des produits ayant obtenu de bonnes notes de la part des experts et des consommateurs.
- Olympus Stop Mould sans danger pour les personnes et les animaux domestiques. Convient pour le traitement de tous matériaux et revêtements de finition.
- Dali Il soulagera la moisissure et la mousse. Le médicament ne peut pas être lavé.
- Atlas Mykos élimine les moisissures, les infections fongiques, les lichens, la mousse. Il peut être utilisé dans des pièces très humides. Disponible sous la forme d'un concentré, qui doit être dilué avec de l'eau.
- Fongicide Spectre peut être utilisé à l'intérieur et sur les façades. Convient pour le plâtre, les structures en bois et les surfaces peintes.
- "Fongicide au titane" peut être utilisé à l'intérieur et à l'extérieur du bâtiment. Lors du traitement du médicament, il n'est pas nécessaire de retirer la couche de peinture.
Avant d’utiliser l’un de ces outils, lisez attentivement les instructions. Ne négligez pas les mesures recommandées pour protéger les voies respiratoires, la peau et les yeux. Votre tâche consiste à détruire les moisissures et à ne pas nuire à votre santé. Si vous utilisez un concentré, diluez-le dans les bonnes proportions: une solution trop forte est non seulement nocive pour la santé, mais peut également endommager les structures de construction. N'oubliez pas que vous devez traiter à la fois la zone touchée et la zone adjacente (le champignon se propage très rapidement et les petites colonies peuvent toujours être invisibles dans les zones voisines).
Dans l'annotation à certains fongicides, il est écrit qu'ils peuvent être appliqués sans enlever le revêtement de finition. Dans la phase initiale de l'apparition du champignon, vous pouvez essayer, mais si le problème est allé trop loin, des mesures légères ne seront d'aucun secours, même si le meilleur remède est utilisé. Enlevez la peinture et le papier peint des murs, tapotez le plâtre. Si vous entendez un son sourd, cela signifie qu'il y a des vides dans lesquels des spores se développent déjà.Éliminez toutes les zones exfoliantes, nettoyez la surface avec une brosse en métal, appliquez une préparation antifongique et laissez sécher pendant au moins 5 heures. Couvrir ensuite les zones endommagées avec un apprêt à pénétration profonde, du plâtre et appliquer la couche de finition. Inspectez les meubles et tous les articles en même temps. S'il y a des traces de moisissure, traitez-les avec des fongicides et brûlez les objets qui n'ont pas de valeur particulière.
Astuce
Pour les réparations, il est préférable d'utiliser de la colle aux propriétés antifongiques. Il crée un film protecteur qui empêche l'humidité d'entrer.
Si de très grandes sections du mur sont touchées et que le plâtre s'effrite sous les doigts, seules les réparations majeures de l'appartement vous seront utiles. Éliminez toutes les couches de finition des murs, brique ou béton bien nettoyés avec des brosses et brûlez avec un chalumeau. Traiter soigneusement toutes les surfaces avec des fongicides et après 2 jours seulement, procéder à la finition.
Important!
Avant le travail, assurez-vous de rechercher et d’éliminer les causes de l’humidité. Si cela n'est pas fait, le moule apparaîtra à nouveau. Pour créer une couche de finition, utilisez des peintures au silicate ou à dispersion fongicides qui ne sont pas couvertes par le champignon.
Prévention
Pour éviter l'apparition de champignons, vous devriez déjà bien penser, lors de l'achat d'un appartement, ce que vous souhaitez: économiser, puis dépenser beaucoup d'argent et de nerfs pour faire face à divers problèmes, ou bien payer un montant décent et obtenir un bon logement. Tout d'abord, inspectez tout le bâtiment. Si elle est délabrée, les joints entre les panneaux sont mal scellés, la brique s’effrite en une seule touche - assurez-vous que le champignon y vit et qu’il se sent bien. Vous ne pouvez même pas entrer dans l'appartement. Très probablement, les propriétaires ont fait une présentation. Il y a une semaine, ils ont réparé et collé de nouveaux papiers peints, mais après un certain temps, le moule sera détruit. Il vaut mieux acheter un appartement dans un nouveau bâtiment et prendre immédiatement des mesures préventives.
Les spores de moisissures sont très légères, elles volent dans les airs, dans la rue et dans n’importe quelle pièce, mais pour que la colonie s’enracine sur le mur, certaines conditions sont nécessaires. L'humidité élevée, le manque de soleil et l'air frais viendront au goût du champignon. Pour éviter cela, isolez les coins gelés, fermez les fissures dans les ouvertures. Surveillez l’état des équipements sanitaires: les hottes doivent bien fonctionner et les robinets doivent se fermer hermétiquement. Faites attention aux tuyaux et autres surfaces métalliques dans la salle de bain. Si de la condensation est observée à cet endroit, l’humidité dans la pièce augmente, et même s’il n’ya pas encore de moisissure, elle apparaîtra bientôt.
Astuce
Dans un appartement humide, il est préférable de ne pas installer de fenêtres en plastique scellées. S'il est impossible de s'en passer, faites une bonne ventilation, installez un climatiseur et prenez régulièrement des mesures préventives contre l'apparition de moisissures.
S'il y a des fuites dans le toit ou les joints, demander à la société de gestion de nettoyer le bâtiment. Aucun arbre ou structure ne devrait bloquer vos fenêtres du soleil - si cela se produit, contactez le département d'architecture et d'aménagement paysager. N'oubliez pas de ventiler périodiquement l'appartement, ne séchez pas le linge dans la pièce, ne renversez pas d'eau sur le sol ou sur la table, essuyez-la. Les jours ensoleillés, vous ne devez pas garder les rideaux bien fermés. Pour éviter que la pièce ne soit trop chaude et que les tons clairs n'irritent pas vos yeux, utilisez du tulle ou des stores. Périodiquement pendant le nettoyage humide, essuyez les murs avec du folk ou des préparations anti-moisissures achetées.
Les taches du champignon ne gâchent pas seulement l'apparence des revêtements de finition, elles pénètrent profondément dans les structures des bâtiments et les détruisent. Les micro-organismes sécrètent des toxines nocives pour les voies respiratoires, les articulations et les autres systèmes de l'organisme. Lors de l'achat d'un appartement, soyez très prudent et, si vous avez déjà un logement infecté, n'épargnez pas vos efforts pour vous battre avec un ennemi microscopique. Vous pouvez faire face à la moisissure si vous ne ménagez pas vos forces et vos moyens.